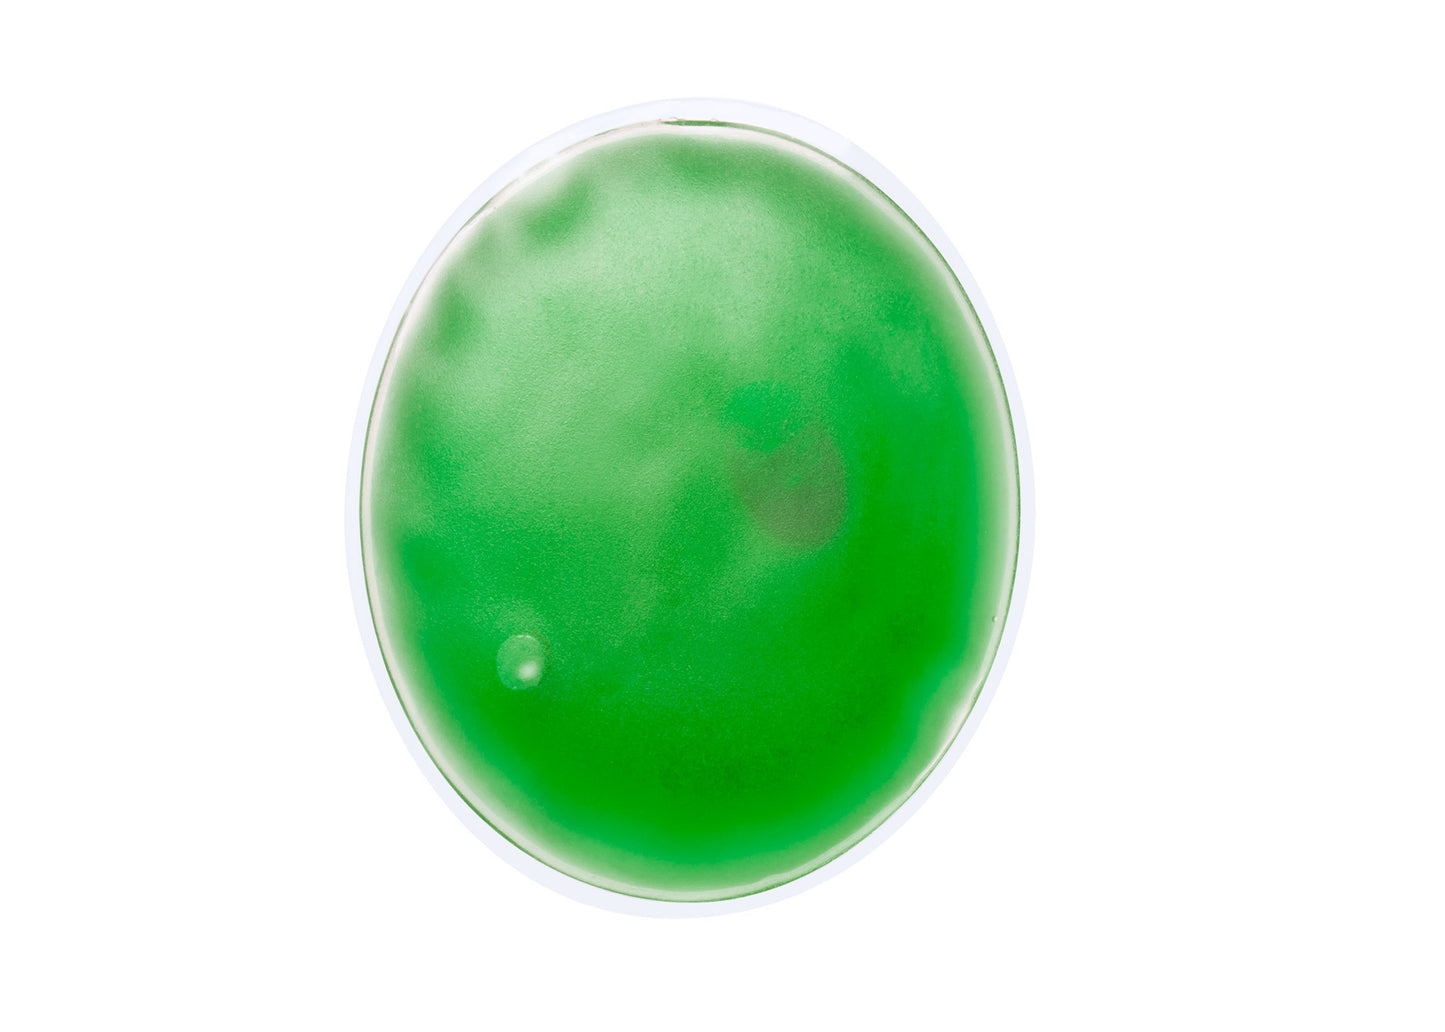

1
/
de
4
Pharma Presents
Chaufferette
Chaufferette
Prix habituel
€0,69 EUR
Prix habituel
Prix promotionnel
€0,69 EUR
Prix unitaire
/
par
Marquage |
50 |
100 | 250 | 500 | 1000 |
Sans | €0,89 HT | €0,79 HT | €0,75 HT | €0,69 HT | €0,59 HT |
Avec | €1,82 HT | €1,15 HT | €1,03 HT | €0,81 HT |
Prix unitaire HT
Franco à partir de 500 €
Pour toute quantité inférieur ou supérieur, merci de nous contacter
Référence : PAP781012
Chaufferette transparente avec gel coloré, réutilisable. Disponible en plusieurs coloris (rose, vert, jaune, bleu, rouge et blanc).Possibilité de mettre un logo ou autre.
Dimensions de marquage: 120 x 80 mm
Délais: 12 à 15 jours ouvrés ( à partir de la validation du BAT, hors jours fériés et période de vacances)
Visuel de marquage fourni par vos soins en format HD ou vectoriel.
Note :
Tous les tarifs sont donnés à titre indicatif et sont susceptibles d'être modifiés en cours d'année et sur réserve des erreurs d'affichage. Tous les visuels affichés sont à titre indicatifs et non contractuels.
Share